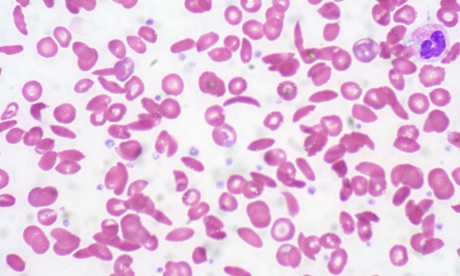
Close-up of blood smear of sickle cell anemia.

Malaria has been around since the dawn of time and shrouded in myth and mystery across history. This first part of a two-part photo series looks at the disease’s beginnings and the early beliefs about how it spread. Humans have repeatedly attempted to treat and eradicate the disease, using numerous less-than-effective means – a far cry from the treatment options of today. The second part of the series will examine the 20th century and more recent advances in malaria prevention, eradication and treatment.
150 million years ago
Parasitic malaria-like ancestors first hitched a ride in a flying invertebrate. Later this free agent with global ambitions developed specialized strains that evolved to target birds, reptiles and mammals. The malaria parasite advanced in Africa tens of millions of years ago, and took a particular interest in primates with more than 25 distinct strains targeting monkeys, chimps, gorillas and us.

12,000 BC
At the dawn of agriculture, malaria made the leap to humans from gorillas and begins taking such a toll that humans evolve blood disorders – such as sickle cell anemia, which reduces the likelihood of malaria infection or death in those with the disorder.
2700 BC
Slaves laboring on Egypt’s pyramids were given large amounts of garlic to ward off illnesses such as malaria. Meanwhile, the pharaohs slept under mosquito-blocking bed nets. This was not enough to protect boy-king Tutankhamen, whose remains showed evidence that he was not only club-footed and suffering from a degenerative bone disease, but killed by malaria.

800 BC
Indian surgeon Sushruta links malaria and insect bites in what would become a foundational Ayurvedic text, the Sushruta Samhita. Too bad the Greeks weren’t reading Sanskrit.

400 BC
Greek doctors assume illnesses such as malaria are a product of miasma, or harmful vapors rising from the ground and carried on the wind. Miasma, meaning “stain” or “pollution” in Greek, is a concept that would take root in the west in the middle ages and hold sway until the 19th century.

200 AD
The physician Galen believes malaria is caused by an imbalance of the body’s humors – blood, phlegm, black bile, and yellow bile – a reflection of the day’s defining medical philosophy. To reestablish balance, he recommends bleeding and purging. Such painful, and dangerous, treatments would remain in vogue within western medicine for more than 1,500 years. A strong believer in the curative power of opposites, Galen also recommends cucumbers for fevers, an easier pill to swallow by far.

300 AD
The herb qinghao, or sweet wormwood, previously used for female hemorrhoids in China, is first prescribed by physician Ge Hong for malaria. Synthesized, herbal derivatives of this herb remain an effective treatment today – particularly against otherwise drug-resistant malaria.

500 AD
The fall of the Roman Empire could have been hastened along by an outbreak of malaria’s more virulent form. A recent discovery of dozens of children’s bodies suggest a calamity severe enough that it may have pushed Rome’s recently Christianized residents back to their pagan roots. Rome had long been known as a hotspot for malaria. In fact, the mosquito-rich marshes outside the city had long helped protect the city from northern invaders whose toleration for the illness was even less than the native Romans.

1250 AD
Dominican scholar Albertus Magnus recommends various alchemical salves. These include baking 77 cakes with the patient’s urine and casting them on a great anthill. The patient was promised to recover as soon as the 77th cake was consumed. This folk cure was likely lifted from a period book of magic. Others involved drinking the blood of a cat mixed in a cup of brandy (seasoned with pepper, naturally) and rubbing the body with wooden chips from the gallows. Meanwhile, the Catholic Church’s “doctrine of signatures” encouraged physicians – since the illness affected the blood – to prescribe red wine and raw red meat.

1600s
The Quechua peoples living in what would became modern-day Peru had been using cinchona bark for centuries to treat malaria before Jesuits brought samples back to Europe. The bark begins to be used medically there in the 1600s, but remains hard to come by and costly. As the plants are transplanted to various points, quinine becomes increasingly popular, remaining the preferred treatment until the 1940s. In fact, some believe the colonization of Africa, Asia, and the Americas simply could not have happened without it. “In the west, this was really the first magic bullet that was actually effective,” said Frank Snowden, Yale University professor in the history of medicine and author of The Conquest of Malaria: Italy, 1900-1962. Today, quinine is used to treat arthritis, lupus and some extreme malaria cases. It is also a flavor agent of tonic waters.

The second part of this series, which examines more recent history, will be coming soon.
Copy on this page is brought to you by SC Johnson, sponsor of An apple a day series and the values-led business hub.







